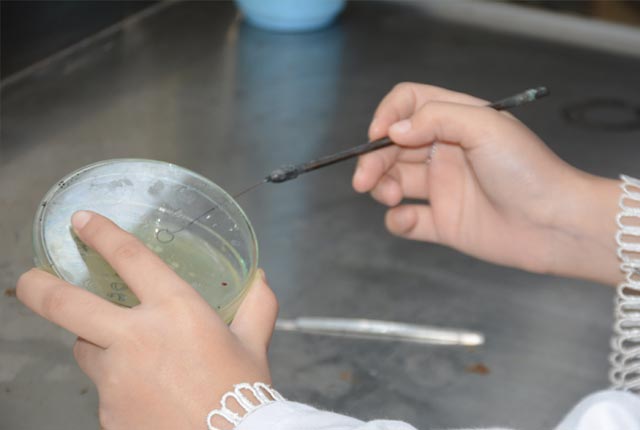

About Us
Sindh Madressatul Islam university is a historical institution that has continued to provide it services in field of education since its establishment in 1885. It attained the status of a charted university by government of Sindh in 2012. Department of Environmental Sciences offers degree program in field of Environmental Sciences at the graduate and post graduate level. In 2023 the Environmental Sciences lab of Department attained the status of SEPA (Sindh Environmental protection Agency) certified laboratory for water (waste water and potable water) testing and noise level
Our Aims and Objectives
The objective of the SMIU Laboratory policy to provide support and strengthening the public and private sector and academia to avail testing facilities including water, waste water, noise and others related physical and biological parameters testing under the concept of “Reliable and Reasonable services “ for all and ensure sustainable services which are in line with National Environmental Quality Standard (NEQS) and Sindh Environmental Quality Standard (SEQS) to fulfill the need of industries and related organization.
Why Work With Us
The SMIU environmental lab specializes in studying samples of drinking water, waste water (effluent) and noise level. Analyzing the environmental factors in it to detect chemical components, Microbiological and noise pollution, to ensure compliance with agreed environmental conditions and standards.
Research Area


Portable Water